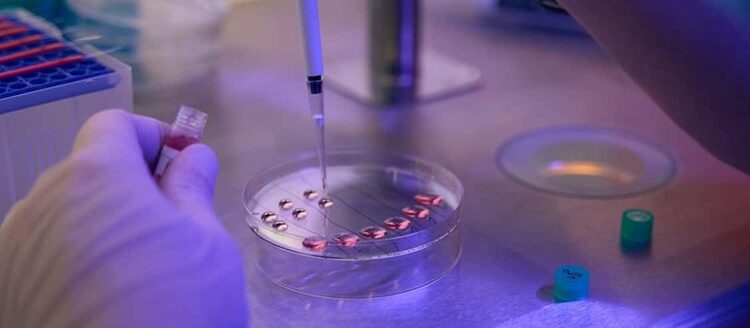
A Speculative Exploration of GHRP and CJC-1295 Synergy in Research Contexts

Within contemporary peptide science, combinations of signaling peptides are increasingly examined not as additive components but as coordinated systems with the potential of shaping endocrine communication across the organism. Among these, the conceptual pairing of growth hormone–releasing peptides (GHRPs) with the growth hormone–releasing hormone analog CJC-1295 has attracted sustained theoretical interest. Investigations purport that this blend may influence pulsatile signaling architecture, receptor-level responsiveness, and temporal coordination of anabolic and metabolic messaging in research models. This article explores the molecular logic behind the GHRP and CJC-1295 peptide blend, emphasizing structural properties, receptor interactions, and hypothesized research applications, while maintaining a speculative, systems-oriented lens.
Introduction: From Singular Peptides to Coordinated Signaling Systems
Peptide research has gradually shifted away from viewing individual peptides as isolated signaling triggers. Instead, research increasingly frames peptides as informational modulators embedded within dynamic regulatory networks. Within this paradigm, combinations of peptides are theorized to provide insights into how biological systems integrate parallel signals to produce coherent outputs.
The pairing of GHRPs with CJC-1295 represents a compelling example of this shift. Rather than being examined solely for isolated signaling potential, this blend is increasingly discussed as a coordinated endocrine stimulus that may engage multiple regulatory layers simultaneously. Research indicates that such coordination may hold relevance for understanding rhythmic hormone release, receptor cross-talk, and adaptive signaling precision within the organism.
Molecular Identity of Growth Hormone–Releasing Peptides
Growth hormone–releasing peptides constitute a class of synthetic oligopeptides originally designed to stimulate growth hormone secretion through mechanisms distinct from endogenous growth hormone–releasing hormone. Structurally diverse, GHRPs are unified by their potential to interact with the growth hormone secretagogue receptor, also known as the ghrelin receptor.
At the molecular level, GHRPs are characterized by compact amino acid sequences that favor receptor binding through hydrophobic and electrostatic interactions. Investigations suggest that their structural simplicity may confer rapid receptor engagement and signal initiation. Unlike classical hypothalamic peptides, GHRPs may operate independently of growth hormone–releasing hormone pathways, offering an alternative route for endocrine stimulation in research models.
Importantly, GHRPs are hypothesized to influence not only growth hormone release but also broader neuroendocrine integration. Research indicates that ghrelin receptor activation may intersect with pathways involved in appetite signaling, circadian rhythm coordination, and stress-response modulation, positioning GHRPs as multifunctional signaling agents rather than single-purpose triggers.
Structural and Functional Characteristics of CJC-1295
CJC-1295 is a synthetic analog of endogenous growth hormone–releasing hormone engineered to enhance molecular stability and prolong signaling duration. Its defining structural feature is the modification that is thought to enable reversible binding to circulating proteins, particularly albumin, within the organism. This property is theorized to extend the peptide’s functional presence and influence temporal signaling dynamics.
At the receptor level, CJC-1295 retains affinity for the growth hormone–releasing hormone receptor, initiating intracellular cascades associated with cyclic AMP production and transcriptional regulation. Research suggests that this pathway might support not only growth hormone release but also the maintenance of pulsatile secretion patterns, which are increasingly studied as critical for downstream signaling fidelity.
Unlike shorter-acting GHRH fragments, CJC-1295 is often discussed in research literature as a temporal regulator rather than a simple stimulant. Its prolonged interaction window may allow for sustained receptor engagement, potentially influencing feedback sensitivity and receptor recycling processes within endocrine tissues.
Conceptual Basis for Peptide Blending
The theoretical rationale for combining GHRPs with CJC-1295 arises from their distinct yet complementary mechanisms of action. While GHRPs engage the ghrelin receptor, CJC-1295 targets the growth hormone–releasing hormone receptor. Research indicates that simultaneous activation of these parallel pathways may converge at the level of pituitary signaling, amplifying informational throughput without relying on a single receptor system. Investigations purport that such convergence may enhance signal robustness while preserving physiological rhythm. Rather than flattening hormonal output into a continuous stream, the blend is hypothesized to reinforce natural pulsatility by synchronizing upstream cues. This distinction is significant, as pulsatile signaling has been associated with improved receptor sensitivity and reduced desensitization in research contexts.
Receptor Cross-Talk and Intracellular Integration
At the cellular level, receptor cross-talk represents a central theme in peptide blend research. Activation of the ghrelin receptor by GHRPs initiates intracellular calcium mobilization and protein kinase pathways, while growth hormone–releasing hormone receptor engagement by CJC-1295 seems to primarily influence cyclic AMP signaling. Research suggests that these pathways may intersect downstream, shaping transcriptional responses and hormone release dynamics.
It has been hypothesized that such intersection allows the organism to integrate metabolic, nutritional, and circadian information into a unified endocrine response. Studies suggest that by engaging distinct receptors, the peptide blend may reduce reliance on any single signaling axis, potentially enhancing adaptability in fluctuating research environments.
Conclusion
The GHRP and CJC-1295 peptide blend occupies a distinctive position within contemporary peptide science. Through complementary receptor engagement, temporal coordination, and network-level integration, this combination is theorized to influence endocrine signaling in ways that transcend simple stimulation. Research indicates that its value lies not merely in the magnitude of response but in the quality, rhythm, and coherence of signaling across the organism. Researchers interested in learning more are encouraged to read this study.
References
[i] Bowers, C. Y., Momany, F. A., Reynolds, G. A., & Hong, A. (1984). On the in vitro and in vivo activity of a synthetic hexapeptide that acts on the pituitary to specifically release growth hormone. Endocrinology, 114(5), 1537–1545. https://doi.org/10.1210/endo-114-5-1537
[ii] Smith, R. G., Van der Ploeg, L. H. T., Howard, A. D., Feighner, S. D., Cheng, K., Hickey, G. J., … Patchett, A. A. (1997). Peptidomimetic regulation of growth hormone secretion. Endocrine Reviews, 18(5), 621–645. https://doi.org/10.1210/edrv.18.5.0319
[iii] Howard, A. D., Feighner, S. D., Cully, D. F., Arena, J. P., Liberator, P. A., Rosenblum, C. I., … Van der Ploeg, L. H. T. (1996). A receptor in pituitary and hypothalamus that functions in growth hormone release. Science, 273(5277), 974–977. https://doi.org/10.1126/science.273.5277.974
[iv] Teichman, S. L., Neale, A., Lawrence, B., Gagnon, C., Castaigne, J. P., Frohman, L. A., & Bowers, C. Y. (2006). Prolonged stimulation of growth hormone secretion by CJC-1295, a long-acting analog of growth hormone-releasing hormone. The Journal of Clinical Endocrinology & Metabolism, 91(3), 799–805. https://doi.org/10.1210/jc.2005-1542
[v] Veldhuis, J. D., Roemmich, J. N., Richmond, E. J., Rogol, A. D., Lovejoy, J. C., Sheffield-Moore, M., … Bowers, C. Y. (2005). Endocrine control of body composition in infancy, childhood, and puberty. Endocrine Reviews, 26(1), 114–146. https://doi.org/10.1210/er.2003-0038